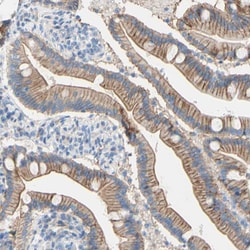
Invitrogen TMIGD2 Polyclonal Antibody 100 &mu;L | Buy Online | Invitrogen&trade; | Fisher Scientific

missing translation for 'onlineSavingsMsg'
Learn More
Learn More
Description
Immunogen sequence: CQVDQATAWE RLRVKWTKDG AILCQPYITN GSLSLGVCGP QGRLSWQAPS HLTLQLDPVS LNHSGAYVCW AAVEIPELEE AEGNITRLFV DPDDPTQNRN RIA Highest antigen sequence identity to the following orthologs: Mouse - 23%, Rat - 23%.
TMIGD2 (transmembrane and immunoglobulin domain containing 1), also known as immunoglobulin-containing and proline-rich receptor 1 (IGPR1), is novel adhesion molecule that is expressed in multiple tissues, primarily in cells of epithelium and endothelium origins. TMIGD2 is thought to be involved in angiogenesis and regulates cellular morphology, homophilic cell aggregation, and cell-cell interaction. TMIGD2 activity also modulates actin stress fiber formation and focal adhesion and reduces cell migration.

Specifications
Specifications
| Antigen | TMIGD2 |
| Applications | Immunohistochemistry (Paraffin), Western Blot |
| Classification | Polyclonal |
| Concentration | 0.2 mg/mL |
| Conjugate | Unconjugated |
| Formulation | PBS with 40% glycerol and 0.02% sodium azide; pH 7.2 |
| Gene | TMIGD2 |
| Gene Accession No. | Q96BF3 |
| Gene Alias | CD28 homolog; CD28 homologue; CD28H; IGPR1; IGPR-1; Immunoglobulin and proline-rich receptor 1; immunoglobulin-containing and proline-rich receptor 1; immunoglobulin-containing and proline-rich receptor-1; TMIGD2; transmembrane and immunoglobulin domain containing 2; transmembrane and immunoglobulin domain-containing protein 2; transmembrane and immunoglobulin domain-containing protein 2 variant 2; transmembrane and immunoglobulin domain-containing protein 2 variant 3; UNQ3059/PRO9879 |
| Gene Symbols | TMIGD2 |
| Show More |
Product Title
By clicking Submit, you acknowledge that you may be contacted by Fisher Scientific in regards to the feedback you have provided in this form. We will not share your information for any other purposes. All contact information provided shall also be maintained in accordance with our Privacy Policy.
Spot an opportunity for improvement?